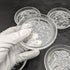
英国ヴィンテージ カットガラス スモールディッシュ 5個セット

英国ヴィンテージ カットガラス スモールディッシュ 5個セット
SKU: 169751715
※日本国外への発送では受取時に別途関税が発生します
英国ヴィンテージのカットガラスの小皿セットをご紹介いたします。
美しくカットされたガラスによる小さな小皿のセットです。
皿面には美しい花のレリーフが施されています。
製造年は不明で比較的新しいものだと思います。
使用感もほとんどなく擦れ傷もない美品です。
この素敵なヴィンテージがあなたの毎日に彩りを与えてくれることを願っています!
https://youtu.be/UULnuYMqC2M
【コンディション】
外観:★★★★☆ 目立った傷や汚れのない美品
機能:★★★★☆ わずかな劣化はあるがほとんど問題ない
・全体的にわずかな経年の摩耗はありますが使用がほとんどない美品です。
・ガラスの欠けやヒビはありません。
※とても古いものですので経年による細かな傷や汚れはございます。
写真をご確認いただき、ご了承いただいたうえで購入をお願い致します。
【詳細】
・メーカー 不明
・製造年 不明
・材質 ガラス
・サイズ 直径90 x 高さ16 mm
・重量 483g(5個合計)
※アンティーク品ですので全く同じものは他にありません
不明な点がありましたらなんでもお気軽にご質問ください。